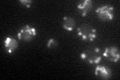
YJL104W

View description
Constituent of the import motor (PAM complex) component of the Translocase of the Inner Mitochondrial membrane (TIM23 complex); forms a 1:1 subcomplex with Pam18p and inhibits its cochaperone activity; contains a J-like domain
Localization:
Intensity:
Fold change:
Significance:
-
C’ GFP library in SD

mitochondria89.62 -
N' NOP1pr-GFP in SD

mitochondria72.4885 -
N' TEF2pr-mCherry in SD

missing0 -
N' NATIVEpr-GFP in SD

missing0 -
N' TEF2pr-VC and Cyto-VN in SD

#N/A0 -
C’ GFP library in SD+DTT

mitochondria87.720.97No -
C’ GFP library in SD+H2O2

mitochondria61.010.68No -
C’ GFP library in Starvation Media
mitochondria61.520.68No -
C’ GFP library on the background of Pup2-DaMP

N/A -
C’ GFP library on the background of CCT mutant

N/A0N/AYes
